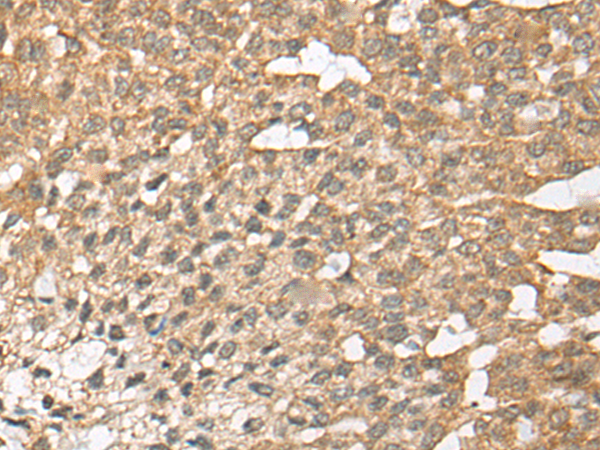

|
Background: |
This gene encodes an arginyltransferase, an enzyme that is involved in posttranslational conjugation of arginine to N-terminal aspartate or glutamate residues. Conjugation of arginine to the N-terminal aspartate or glutamate targets proteins for ubiquitin-dependent degradation. Alternative splicing results in multiple transcript variants. |
|
Applications: |
ELISA, WB, IHC |
|
Name of antibody: |
ATE1 |
|
Immunogen: |
Synthetic peptide of human ATE1 |
|
Full name: |
arginyltransferase 1 |
|
SwissProt: |
O95260 |
|
ELISA Recommended dilution: |
5000-10000 |
|
IHC positive control: |
Human liver cancer and human esophagus cancer |
|
IHC Recommend dilution: |
30-150 |
|
WB Predicted band size: |
59 kDa |
|
WB Positive control: |
A549 and HEPG2 cell lysates |
|
WB Recommended dilution: |
500-2000 |

購物車
購物車 幫助
幫助
 021-54845833/15800441009
021-54845833/15800441009
